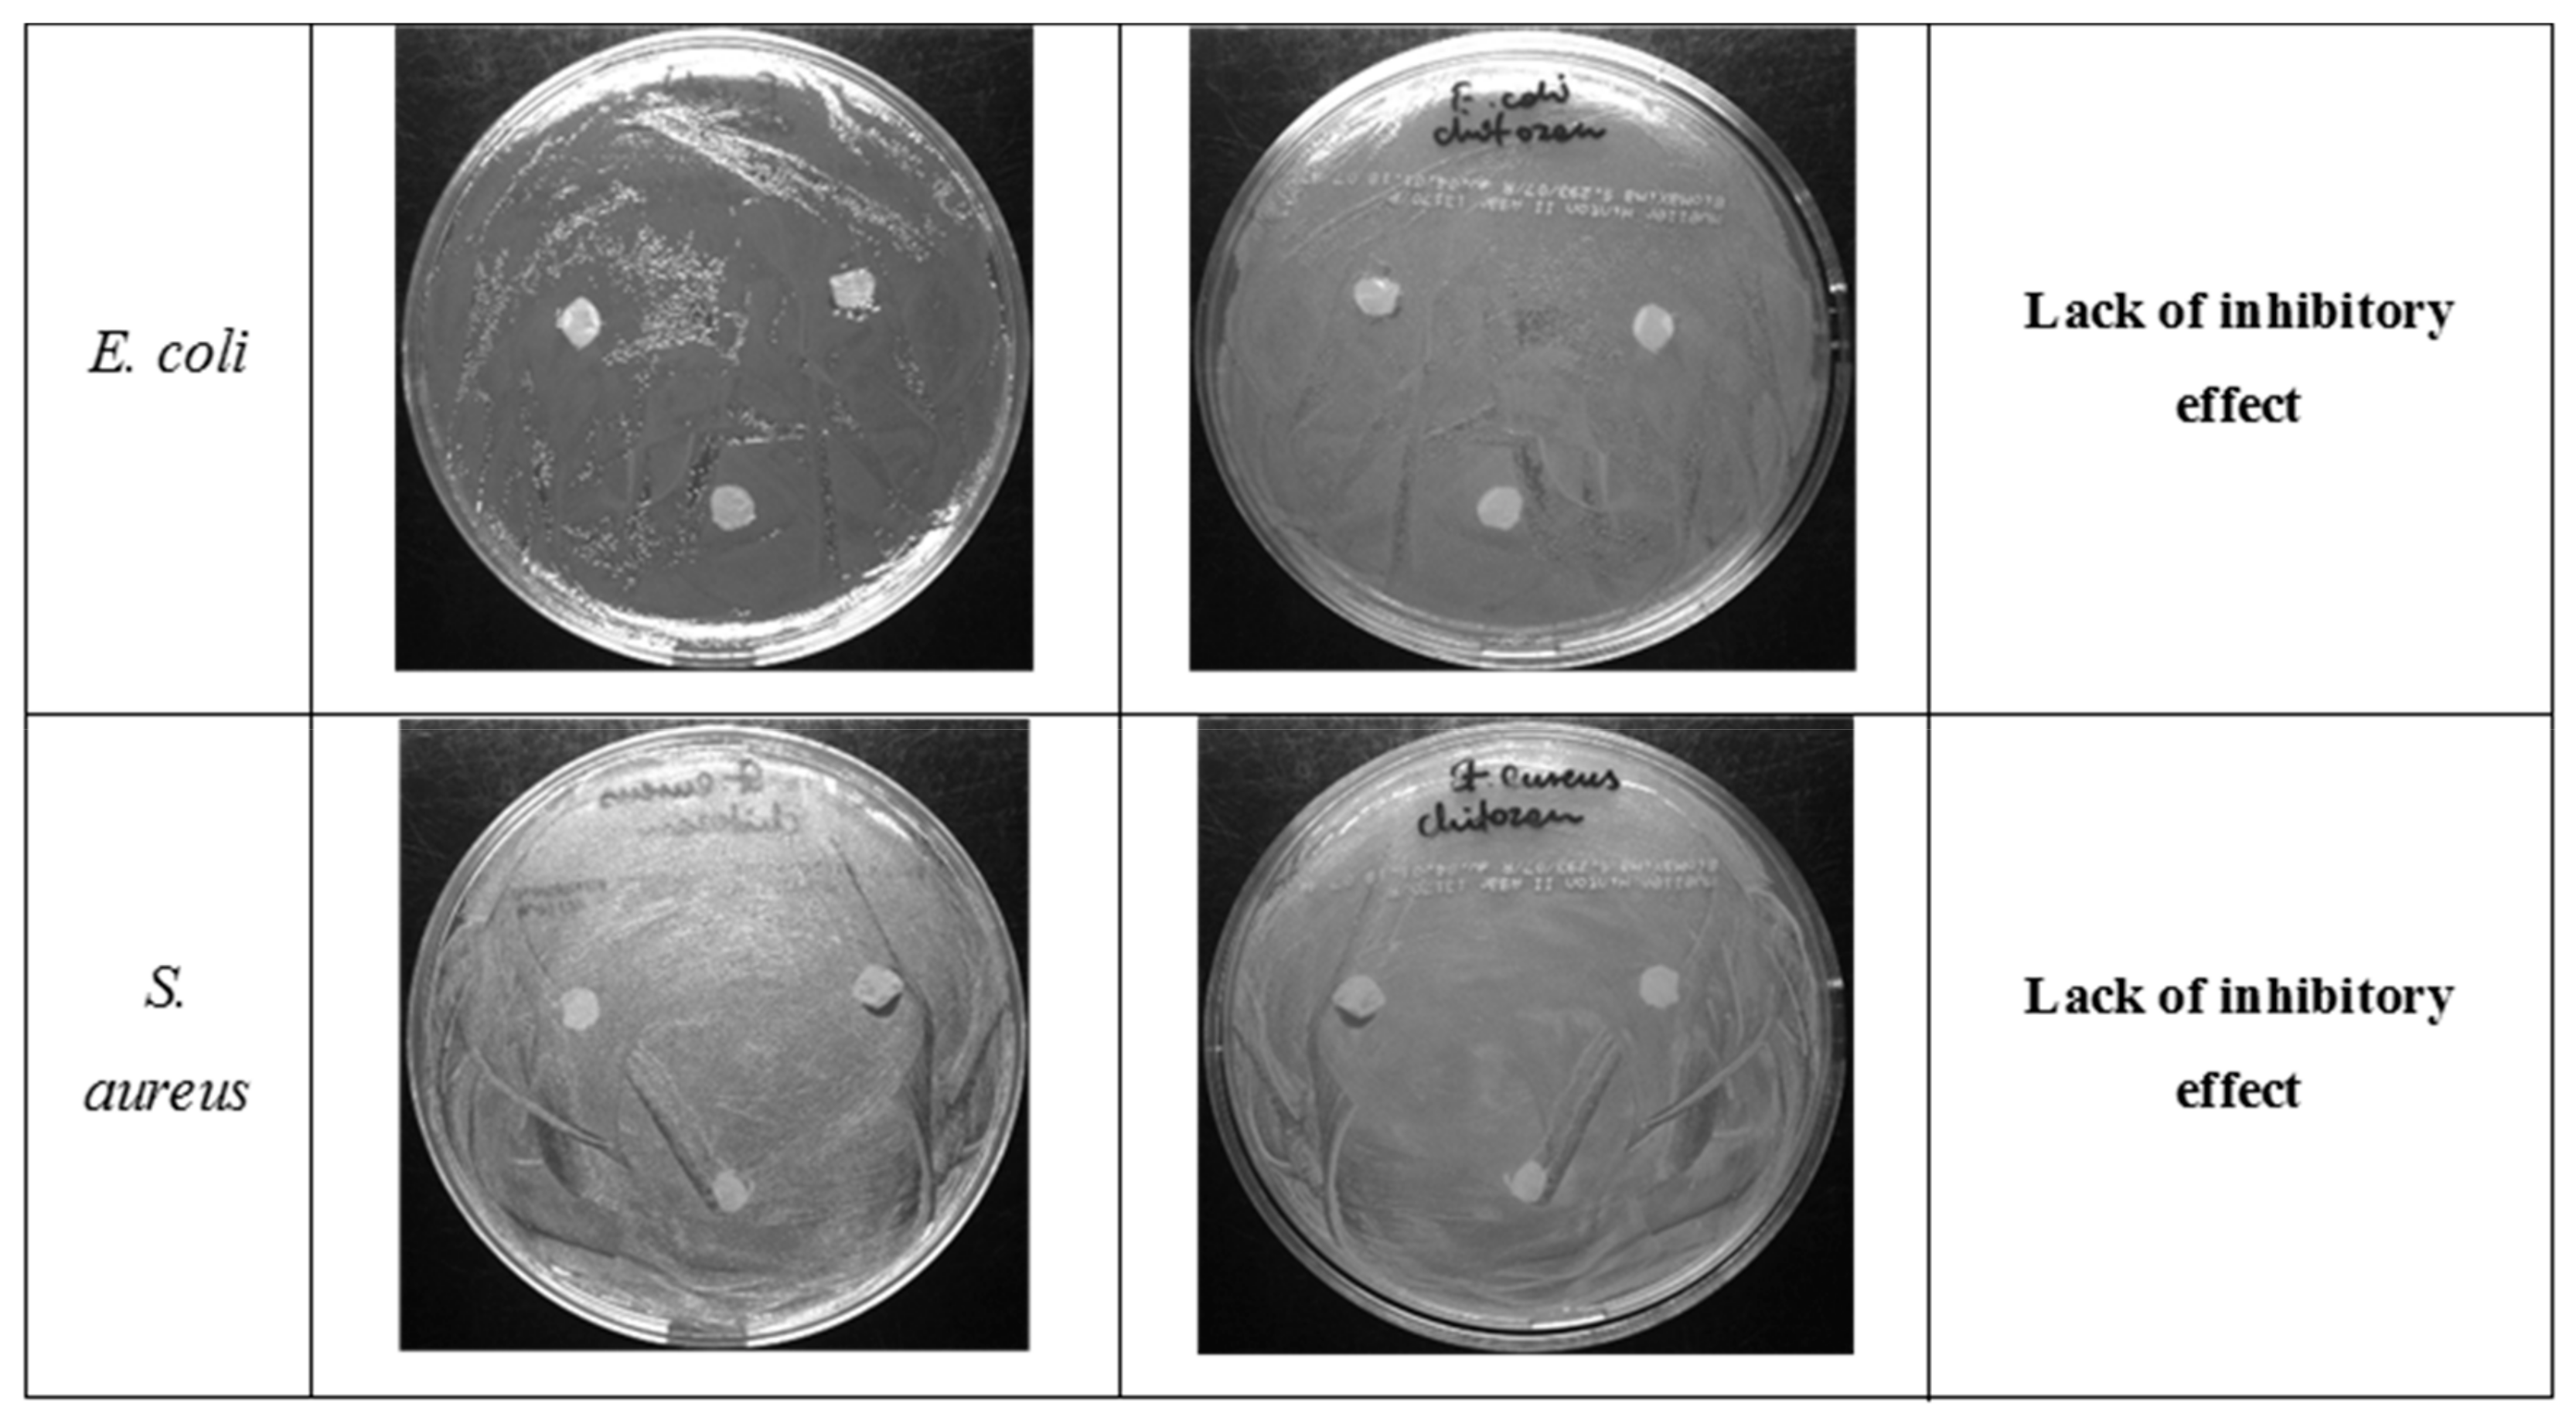
Ijms 21 00166 g009 Ijms 21 00166 g009
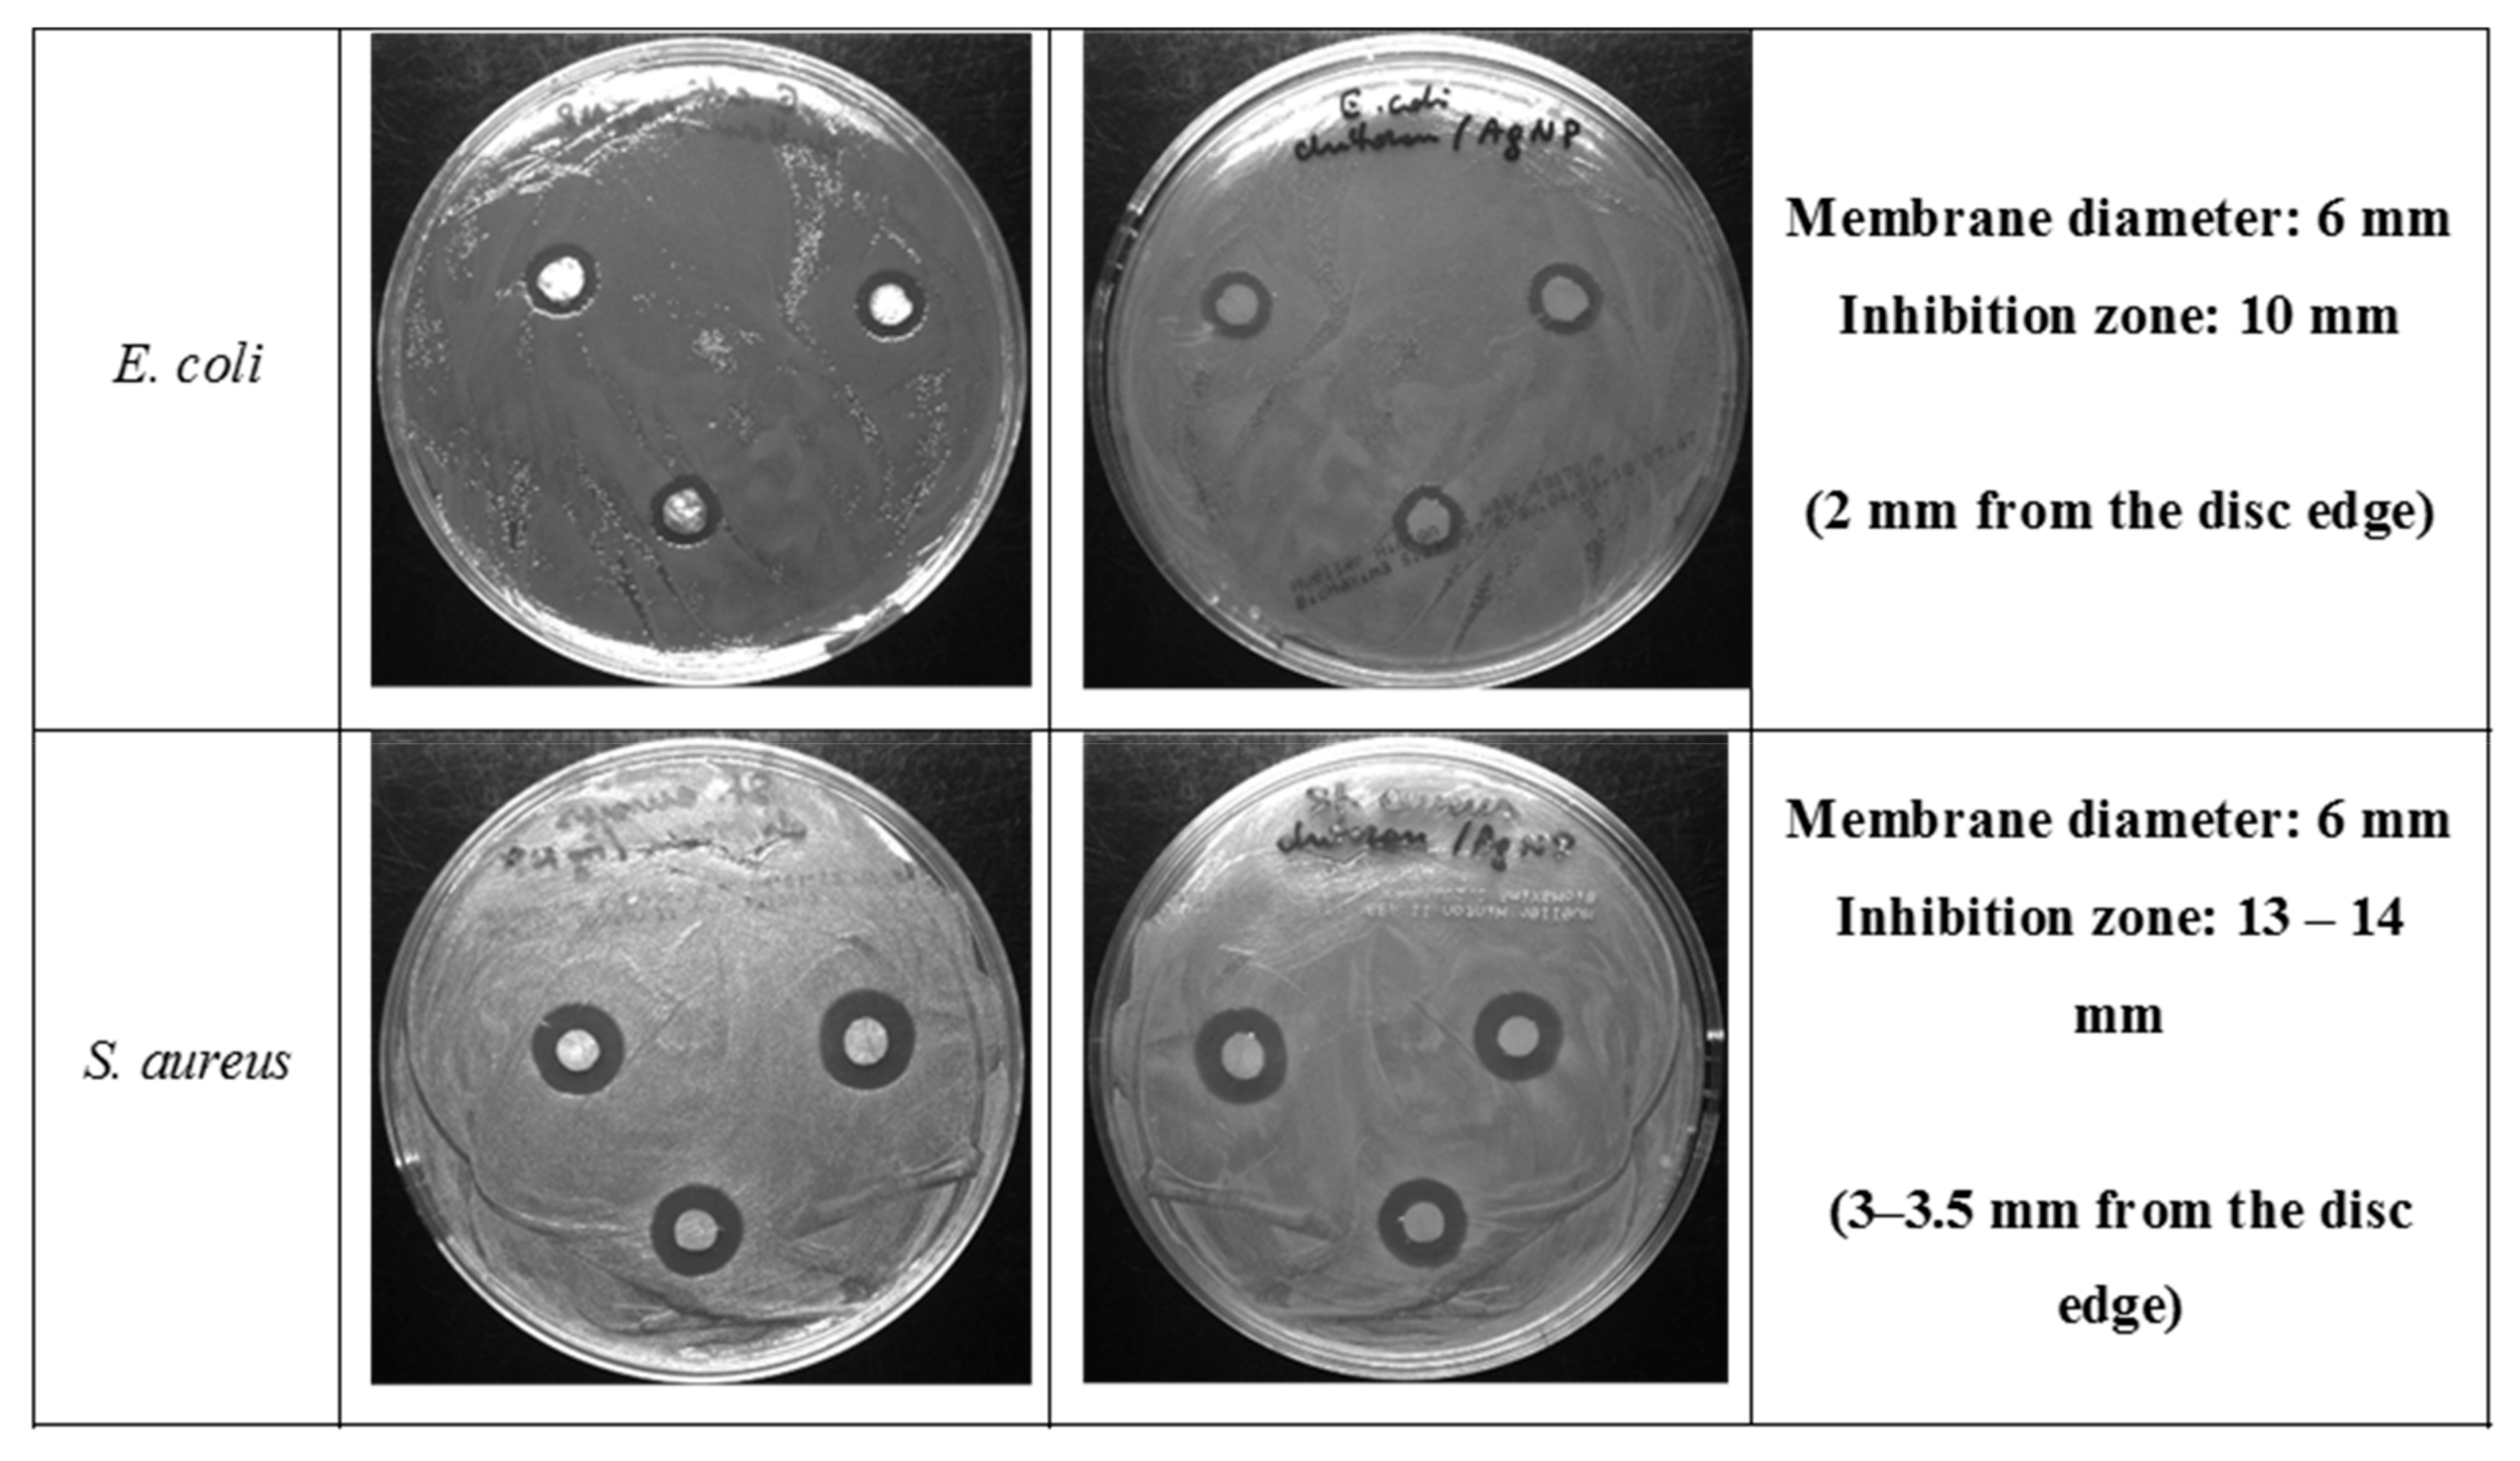
Ijms 21 00166 g010 Ijms 21 00166 g010
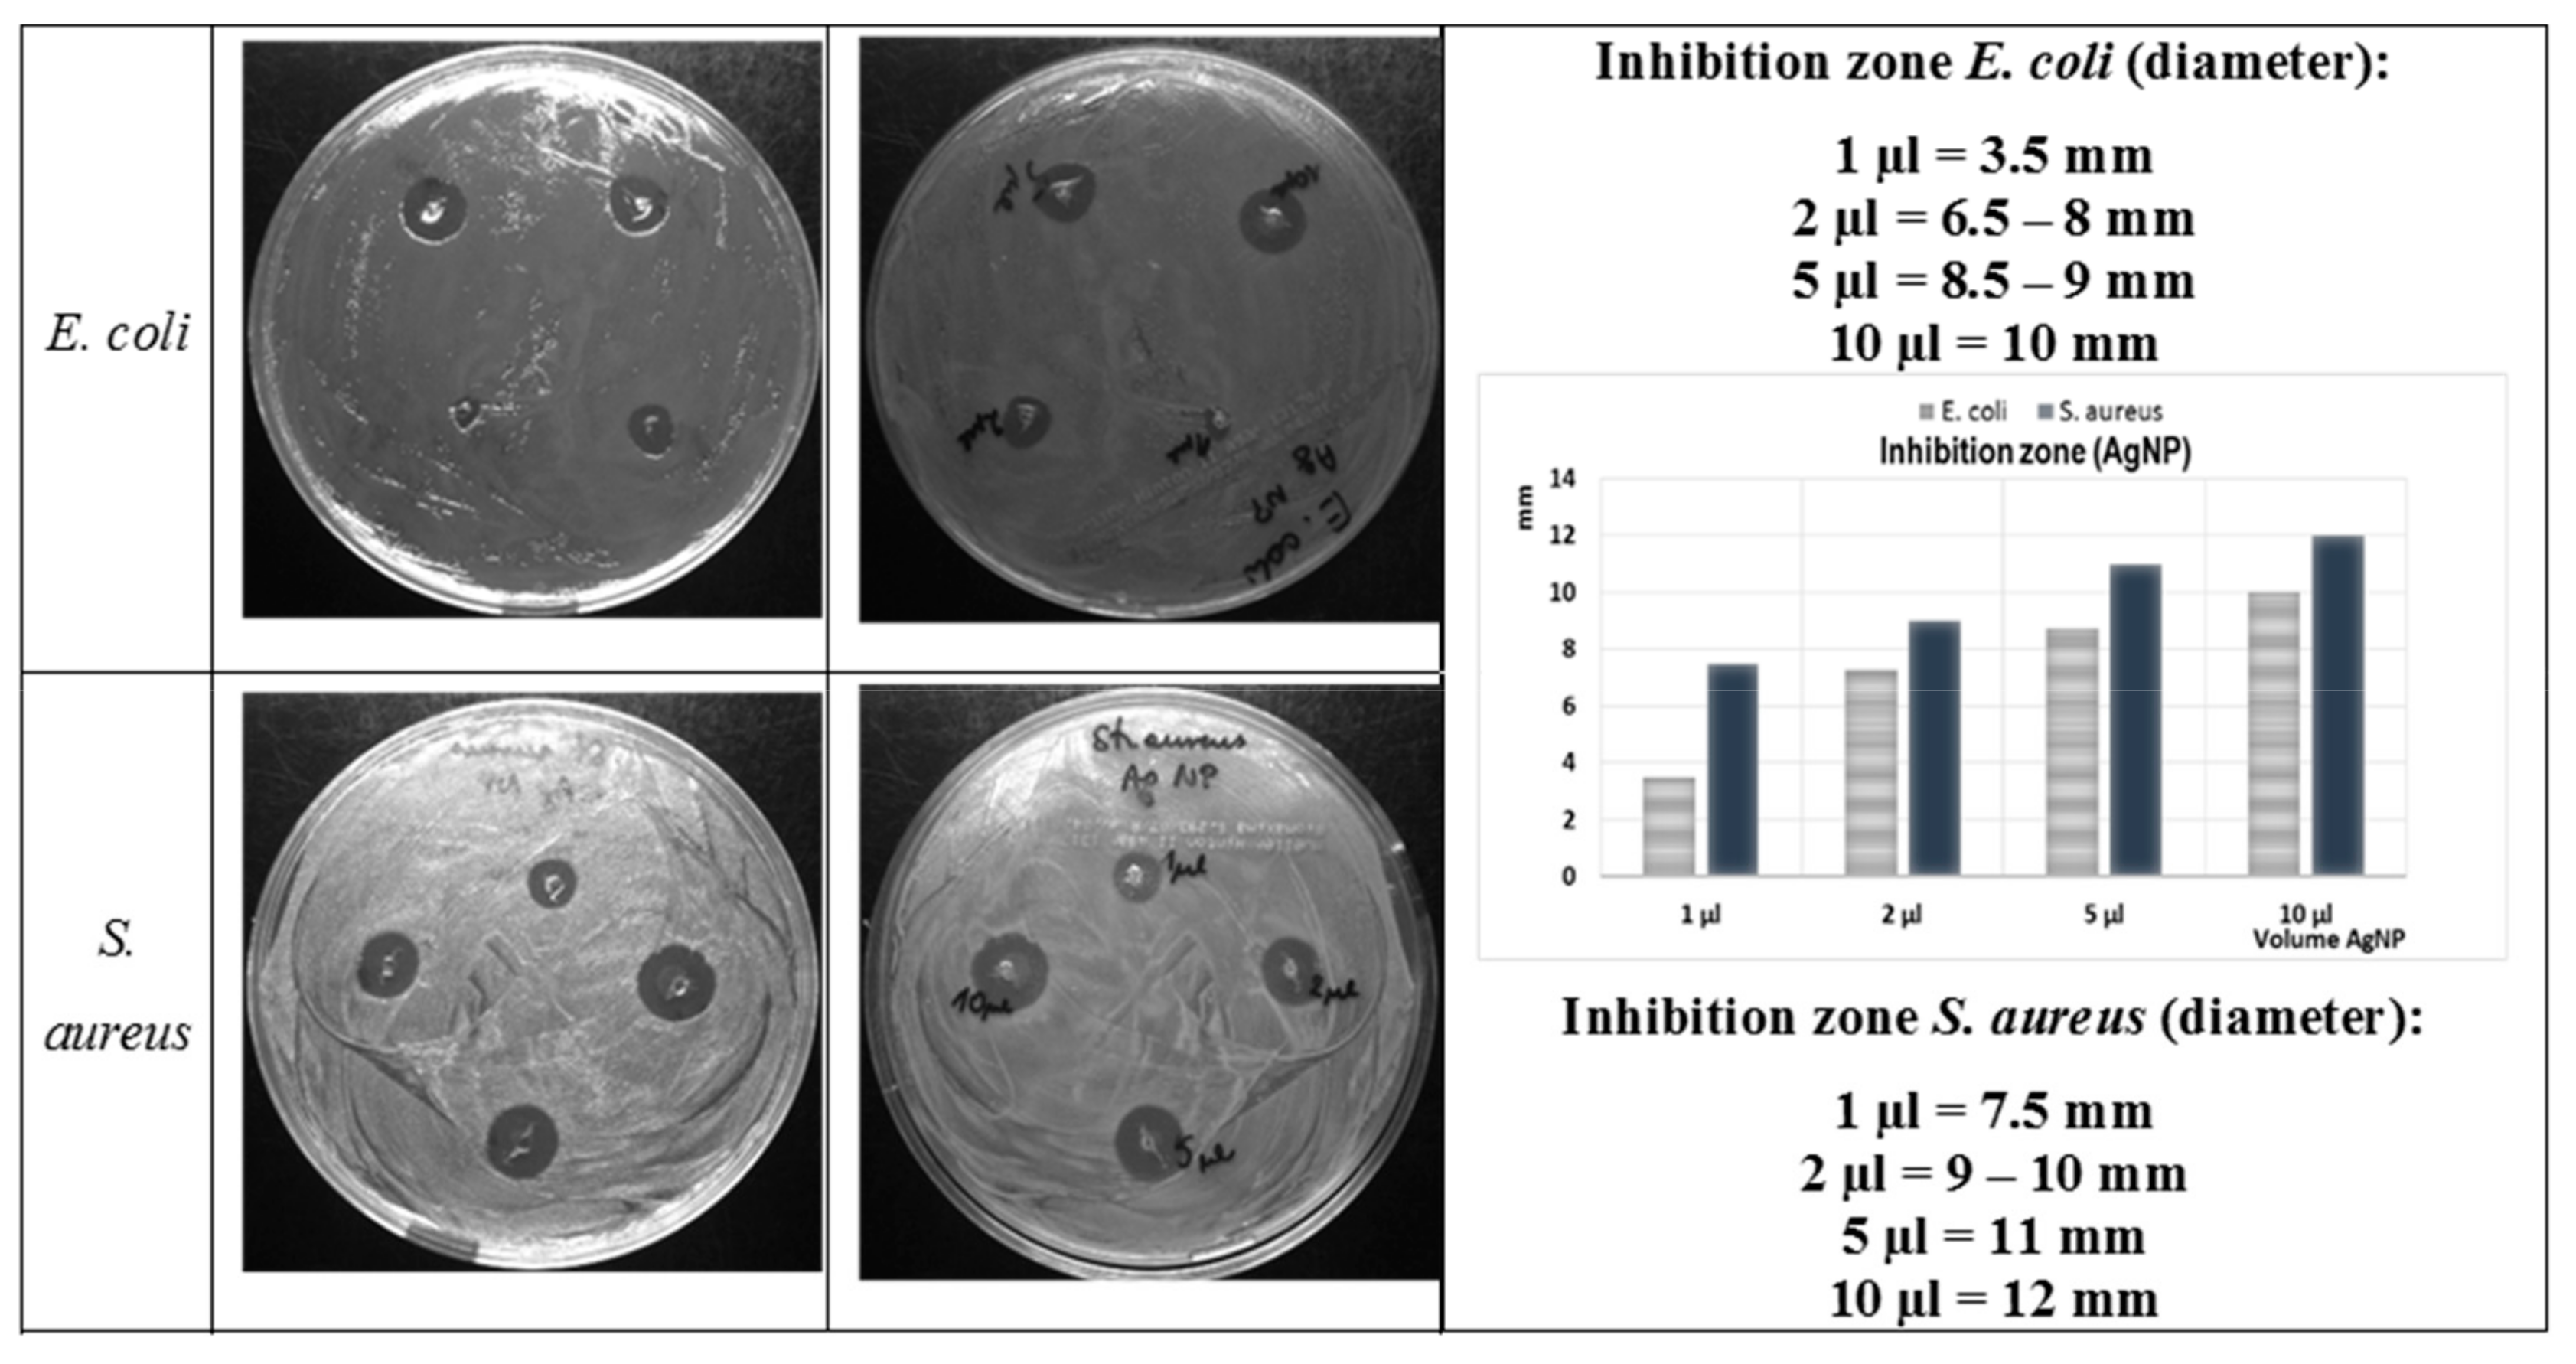
Ijms 21 00166 g011 Ijms 21 00166 g011

Silver Nanoparticles on Chitosan/Silica Nanofibers: Characterization and Antibacterial Activity
Abstract
1. Introduction
2. Results and Discussion
2.1. Characterization of the AgNP solution
2.1.1. Microstructural characterization of Ag/CS/silica nanofibers
2.1.2. Textural Properties of Nanofibers
2.2. Morphological Studies of Ag/CS/Silica Nanofibers
2.3. Antibacterial Activity of Ag/CS/Silica Nanocomposites
3. Materials and Methods
3.1. Reagents
3.2. Preparation of CS/Silica Nanocomposites by Electrospinning
3.3. Preparation of the Diammine Silver Precursor and the Colloidal Silver Solution (AgNP)
3.4. Preparation of the Ag/CS/silica Composites
3.5. Antibacterial Activity Assay and Minimum Inhibitory Concentration (MIC) of AgNP Solution Determination
3.6. Measurements and Calculations
4. Conclusions
Author Contributions
Funding
Conflicts of Interest
References
- Anandhakumar, S.; Mahalakshmi, V.; Raichur, A.M. Silver nanoparticles modified nanocapsules for ultrasonically activated drug delivery. Mater. Sci. Eng. C 2012, 32, 2349–2355. [Google Scholar] [CrossRef]
- Chen, G.; Lu, J.; Lam, C.; Yu, Y. A novel green synthesis approach for polymer nanocomposites decorated with silver nanoparticles and their antibacterial activity. Analyst 2014, 139, 5793–5799. [Google Scholar] [CrossRef] [PubMed]
- Kiroshka, V.V.; Petrova, V.A.; Chernyakov, D.D.; Bozhkova, Y.O.; Kiroshka, K.V.; Baklagina, Y.G.; Romanov, D.P.; Kremnev, R.V.; Skorik, Y.A. Influence of chitosan-chitin nanofiber composites on cytoskeleton structure and the proliferation of rat bone marrow stromal cells. J. Mater. Sci. Mater. Med. 2017, 28, 21. [Google Scholar] [CrossRef] [PubMed]
- Kumar, M.N.; Muzzarelli, R.A.; Muzzarelli, C.; Sashiwa, H.; Domb, A.J. Chitosan chemistry and pharmaceutical perspectives. Chem. Rev. 2004, 104, 6017–6084. [Google Scholar] [CrossRef] [PubMed]
- Petrova, V.A.; Elokhovskiy, V.Y.; Raik, S.V.; Poshina, D.N.; Romanov, D.P.; Skorik, Y.A. Alginate gel reinforcement with chitin nanowhiskers modulates rheological properties and drug release profile. Biomolecules 2019, 9, 291. [Google Scholar] [CrossRef]
- Rana, V.K.; Choi, M.C.; Kong, J.Y.; Kim, G.Y.; Kim, M.J.; Kim, S.H.; Mishra, S.; Singh, R.P.; Ha, C.S. Synthesis and drug-delivery behavior of chitosan-functionalized graphene oxide hybrid nanosheets. Macromol. Mater. Eng. 2011, 296, 131–140. [Google Scholar] [CrossRef]
- Rao, K.M.; Rao, K.S.; Ramanjaneyulu, G.; Rao, K.C.; Subha, M.C.; Ha, C.S. Biodegradable sodium alginate-based semi-interpenetrating polymer network hydrogels for antibacterial application. J. Biomed. Mater. Res. 2014, 102, 3196–3206. [Google Scholar]
- Sarin, S.; Kolesnikova, S.; Postnova, I.; Ha, C.S.; Shchipunov, Y. Bionanocomposite from self-assembled building blocks of nacre-like crystalline polymorph of chitosan with clay nanoplatelets. RSC Adv. 2016, 6, 33501–33509. [Google Scholar] [CrossRef]
- Gaafar, M.R.; Mady, R.F.; Diab, R.G.; Shalaby, T.I. Chitosan and silver nanoparticles: Promising anti-toxoplasma agents. Exp. Parasitol. 2014, 143, 30–38. [Google Scholar] [CrossRef]
- Madhumathi, K.; Sudheesh Kumar, P.T.; Abhilash, S.; Sreeja, V.; Tamura, H.; Manzoor, K.; Nair, S.V.; Jayakumar, R. Development of novel chitin/nanosilver composite scaffolds for wound dressing applications. J. Mater. Sci. Mater. Med. 2010, 21, 807–813. [Google Scholar] [CrossRef]
- Huang, Y.; Miao, Y.E.; Ji, S.; Tjiu, W.W.; Liu, T. Electrospun carbon nanofibers decorated with ag-pt bimetallic nanoparticles for selective detection of dopamine. ACS Appl. Mater. Interfaces 2014, 6, 12449–12456. [Google Scholar] [CrossRef] [PubMed]
- Severyukhina, A.N.; Parakhonskiy, B.V.; Prikhozhdenko, E.S.; Gorin, D.A.; Sukhorukov, G.B.; Mohwald, H.; Yashchenok, A.M. Nanoplasmonic chitosan nanofibers as effective sers substrate for detection of small molecules. ACS Appl. Mater. Interfaces 2015, 7, 15466–15473. [Google Scholar] [CrossRef] [PubMed]
- Anuradha, K.; Bangal, P.; Madhavendra, S.S. Macromolecular arabinogalactan polysaccharide mediated synthesis of silver nanoparticles, characterization and evaluation. Macromol. Res. 2016, 24, 152–162. [Google Scholar] [CrossRef]
- Chen, W.; Zhong, L.; Peng, X.; Lin, J.; Sun, R. Xylan-type hemicelluloses supported terpyridine-palladium(ii) complex as an efficient and recyclable catalyst for suzuki-miyaura reaction. Cellulose 2014, 21, 125–137. [Google Scholar] [CrossRef]
- Xu, W.; Jin, W.; Lin, L.; Zhang, C.; Li, Z.; Li, Y.; Song, R.; Li, B. Green synthesis of xanthan conformation-based silver nanoparticles: Antibacterial and catalytic application. Carbohyd. Polym. 2014, 101, 961–967. [Google Scholar] [CrossRef]
- Huang, J.; Ren, J.; Chen, G.; Deng, Y.; Wang, G.; Wu, X. Evaluation of the xanthan-based film incorporated with silver nanoparticles for potential application in the nonhealing infectious wound. J. Nanomater. 2017, 2017, 6802397. [Google Scholar] [CrossRef]
- Huang, H.; Yuan, Q.; Yang, X. Preparation and characterization of metal-chitosan nanocomposites. Colloids Surf. B 2004, 39, 31–37. [Google Scholar] [CrossRef]
- Porel, S.; Venkatram, N.; Rao, D.N.; Radhakrishnan, T.P. In situ synthesis of metal nanoparticles in polymer matrix and their optical limiting applications. J. Nanosci. Nanotechnol. 2007, 7, 1887–1892. [Google Scholar] [CrossRef]
- Cao, J.; Cao, H.; Zhu, Y.; Wang, S.; Qian, D.; Chen, G.; Sun, M.; Huang, W. Rapid and effective removal of cu(2+) from aqueous solution using novel chitosan and laponite-based nanocomposite as adsorbent. Polymers 2016, 9, 5. [Google Scholar] [CrossRef]
- Guibal, E. Interactions of metal ions with chitosan-based sorbents: A review. Sep. Purif. Technol. 2004, 38, 43–74. [Google Scholar] [CrossRef]
- Muzzarelli, R.A.A. Potential of chitin/chitosan-bearing materials for uranium recovery: An interdisciplinary review. Carbohyd. Polym. 2011, 84, 54–63. [Google Scholar] [CrossRef]
- Sanpui, P.; Murugadoss, A.; Prasad, P.V.; Ghosh, S.S.; Chattopadhyay, A. The antibacterial properties of a novel chitosan-ag-nanoparticle composite. Int. J. Food Microbiol. 2008, 124, 142–146. [Google Scholar] [CrossRef] [PubMed]
- Thomas, V.; Yallapu, M.M.; Sreedhar, B.; Bajpai, S.K. Fabrication, characterization of chitosan/nanosilver film and its potential antibacterial application. J. Biomater. Sci. Polym. Ed. 2009, 20, 2129–2144. [Google Scholar] [CrossRef] [PubMed]
- Yazdani, M.R.; Bhatnagar, A.; Vahala, R. Synthesis, characterization and exploitation of nano-tio2/feldspar-embedded chitosan beads towards uv-assisted adsorptive abatement of aqueous arsenic (as). Chem. Eng. J. 2017, 316, 370–382. [Google Scholar] [CrossRef]
- Poshina, D.N.; Raik, S.V.; Poshin, A.N.; Skorik, Y.A. Accessibility of chitin and chitosan in enzymatic hydrolysis: A review. Polym. Degrad. Stabil. 2018, 156, 269–278. [Google Scholar] [CrossRef]
- Kalaivani, R.; Maruthupandy, M.; Muneeswaran, T.; Hameedha Beevi, A.; Anand, M.; Ramakritinan, C.M.; Kumaraguru, A.K. Synthesis of chitosan mediated silver nanoparticles (ag nps) for potential antimicrobial applications. Front. Lab. Med. 2018, 2, 30–35. [Google Scholar] [CrossRef]
- Potara, M.; Baia, M.; Farcau, C.; Astilean, S. Chitosan-coated anisotropic silver nanoparticles as a sers substrate for single-molecule detection. Nanotechnology 2012, 23, 055501. [Google Scholar] [CrossRef]
- Vimala, K.; Yallapu, M.M.; Varaprasad, K.; Reddy, N.N.; Ravindra, S.; Naidu, N.S.; Raju, K.M. Fabrication of curcumin encapsulated chitosan-pva silver nanocomposite films for improved antimicrobial activity. J. Biomater. Nanobiotechnol. 2011, 2, 55–64. [Google Scholar] [CrossRef]
- Kurita, K. Chitin and chitosan: Functional biopolymers from marine crustaceans. Mar. Biotechnol. 2006, 8, 203–226. [Google Scholar] [CrossRef]
- Raza, M.A.; Kanwal, Z.; Rauf, A.; Sabri, A.N.; Riaz, S.; Naseem, S. Size- and shape-dependent antibacterial studies of silver nanoparticles synthesized by wet chemical routes. Nanomaterials 2016, 6, 74. [Google Scholar] [CrossRef]
- Satyanarayana, M.; Kumar, V.S.; Gobi, K.V. Biopolymer protected silver nanoparticles on the support of carbon nanotube as interface for electrocatalytic applications. AIP Conf. Proc. 2016, 1724, 020097. [Google Scholar]
- Susilowati, E.; Triyono, T.; Santosa, S.J.; Kartini, I. Synthesis of silver-chitosan nanocomposites colloidal by glucose as reducing agent. Indones. J. Chem. 2015, 15, 29–35. [Google Scholar] [CrossRef]
- Palla-Rubio, B.; Araujo-Gomes, N.; Fernandez-Gutierrez, M.; Rojo, L.; Suay, J.; Gurruchaga, M.; Goni, I. Synthesis and characterization of silica-chitosan hybrid materials as antibacterial coatings for titanium implants. Carbohyd. Polym. 2019, 203, 331–341. [Google Scholar] [CrossRef] [PubMed]
- Pandis, C.; Madeira, S.; Matos, J.; Kyritsis, A.; Mano, J.F.; Ribelles, J.L. Chitosan-silica hybrid porous membranes. Mat. Sci. Eng. C Mater. 2014, 42, 553–561. [Google Scholar] [CrossRef] [PubMed]
- Elsabee, M.Z.; Naguib, H.F.; Morsi, R.E. Chitosan based nanofibers, review. Mater. Sci. Eng. C 2012, 32, 1711–1726. [Google Scholar] [CrossRef]
- Kalantari, K.; Afifi, A.M.; Jahangirian, H.; Webster, T.J. Biomedical applications of chitosan electrospun nanofibers as a green polymer—Review. Carbohyd. Polym. 2019, 207, 588–600. [Google Scholar] [CrossRef]
- Petrova, V.A.; Chernyakov, D.D.; Poshina, D.N.; Gofman, I.V.; Romanov, D.P.; Mishanin, A.I.; Golovkin, A.S.; Skorik, Y.A. Electrospun bilayer chitosan/hyaluronan material and its compatibility with mesenchymal stem cells. Materials 2019, 12, 2016. [Google Scholar] [CrossRef]
- Krishnaveni, B.; Ragunathan, R. Extraction and characterization of chitin and chitosan from f.Solani cbnr bkrr, synthesis of their bionanocomposites and study of their productive application. J. Pharma. Sci. Res. 2015, 7, 197–205. [Google Scholar]
- Ryan, C.; Alcock, E.; Buttimer, F.; Schmidt, M.; Clarke, D.; Pemble, M.; Bardosova, M. Synthesis and characterisation of cross-linked chitosan composites functionalised with silver and gold nanoparticles for antimicrobial applications. Sci. Technol. Adv. Mater. 2017, 18, 528–540. [Google Scholar] [CrossRef]
- Bui, V.K.H.; Park, D.; Lee, Y.-C. Chitosan Combined with ZnO, TiO2 and Ag Nanoparticles for Antimicrobial Wound Healing Applications: A Mini Review of the Research Trends. Polymers 2017, 9, 21. [Google Scholar] [CrossRef]
- Kong, M.; Chen, X.G.; Xing, K.; Park, H.J. Antimicrobial properties of chitosan and mode of action: A state of the art review. Int. J. Food Microbiol. 2010, 44, 51–63. [Google Scholar] [CrossRef] [PubMed]
- Susilowati, E. Green synthesis of silver-chitosan nanocomposite and their application as antibacterial material. J. Phys. Conf. Ser. 2019, 1153, 012135. [Google Scholar] [CrossRef]
- Rabea, E.I.; Badawy, M.E.; Stevens, C.V.; Smagghe, G.; Steurbaut, W. Chitosan as antimicrobial agent: Applications and mode of action. Biomacromolecules 2003, 4, 1457–1465. [Google Scholar] [CrossRef] [PubMed]
- Younes, I.; Sellimi, S.; Rinaudo, M.; Jellouli, K.; Nasri, M. Influence of acetylation degree and molecular weight of homogeneous chitosans on antibacterial and antifungal activities. Int. J. Food Microbiol. 2014, 185, 57–63. [Google Scholar] [CrossRef]
- Goy, R.C.; De Britto, D.; Assis, O.B.G. A review of the antimicrobial activity of chitosan. Polimeros 2009, 19, 241–247. [Google Scholar] [CrossRef]
- Kim, S. Competitive biological activities of chitosan and its derivatives: Antimicrobial, antioxidant, anticancer, and anti-inflammatory activities. Int. J. Polym. Sci. 2018, 2018, 1708172. [Google Scholar] [CrossRef]
- Liu, J.; Xiao, Y.; Wang, X.; Huang, L.; Chen, Y.; Bao, C. Glucose-sensitive delivery of metronidazole by using a photo-crosslinked chitosan hydrogel film to inhibit porphyromonas gingivalis proliferation. Int. J. Biol. Macromol. 2019, 122, 19–28. [Google Scholar] [CrossRef]
- Ye, B.L.; Zheng, R.; Ruan, X.J.; Zheng, Z.H.; Cai, H.J. Chitosan-coated doxorubicin nano-particles drug delivery system inhibits cell growth of liver cancer via p53/prc1 pathway. Biochem. Biophys. Res. Commun. 2018, 495, 414–420. [Google Scholar] [CrossRef]
- Mulvaney, P. Surface plasmon spectroscopy of nanosized metal particles. Langmuir 1996, 12, 788–800. [Google Scholar] [CrossRef]
- Liu, L.G.; Bassett, W.A. Compression of ag and phase transformation of nacl. J. Appl. Phys. 1973, 44, 1475–1479. [Google Scholar] [CrossRef]
- Zienkiewicz-Strzałka, M.; Pikus, S. Synthesis of photoactive agcl/sba-15 by conversion of silver nanoparticles into stable agcl nanoparticles. Appl. Surf. Sci. 2013, 265, 904–911. [Google Scholar] [CrossRef]
- Hall, B.D.; Zanchet, D.; Ugarte, D. Estimating nanoparticle size from diffraction measurements. J. Appl. Cryst. 2000, 33, 1335–1341. [Google Scholar] [CrossRef]
- Patterson, A.L. The scherrer formula for X-ray particle size determination. Phys. Rev. 1939, 56, 978–982. [Google Scholar] [CrossRef]
- Baklagina, Y.G.; Klechkovskaya, V.V.; Kononova, S.V.; Petrova, V.A.; Poshina, D.N.; Orekhov, A.S.; Skorik, Y.A. Polymorphic modifications of chitosan. Crystallogr. Rep. 2018, 63, 303–313. [Google Scholar] [CrossRef]
- Kumirska, J.; Czerwicka, M.; Kaczynski, Z.; Bychowska, A.; Brzozowski, K.; Thoming, J.; Stepnowski, P. Application of spectroscopic methods for structural analysis of chitin and chitosan. Marine Drugs 2010, 8, 1567–1636. [Google Scholar] [CrossRef]
- Abdou, E.S.; Nagy, K.S.; Elsabee, M.Z. Extraction and characterization of chitin and chitosan from local sources. Bioresource 2008, 99, 1359–1367. [Google Scholar] [CrossRef]
- Zheng, L.Y.; Zhu, J.F. Study on antimicrobial activity of chitosan with different molecular weights. Carbohyd. Polym. 2003, 54, 527–530. [Google Scholar] [CrossRef]
- Cinteza, L.O.; Scomoroscenco, C.; Voicu, S.N.; Nistor, C.L.; Nitu, S.G.; Trica, B.; Jecu, M.L.; Petcu, C. Chitosan-stabilized ag nanoparticles with superior biocompatibility and their synergistic antibacterial effect in mixtures with essential oils. Nanomaterials 2018, 8, 826. [Google Scholar] [CrossRef]
- Yuan, Y.G.; Peng, Q.L.; Gurunathan, S. Effects of silver nanoparticles on multiple drug-resistant strains of staphylococcus aureus and pseudomonas aeruginosa from mastitis-infected goats: An alternative approach for antimicrobial therapy. Int. J. Mol. Sci. 2017, 18, 569. [Google Scholar] [CrossRef]
- Liao, C.; Li, Y.; Tjong, S.C. Bactericidal and cytotoxic properties of silver nanoparticles. Int. J. Mol. Sci. 2019, 20, 449. [Google Scholar] [CrossRef]
- Liao, S.; Zhang, Y.; Pan, X.; Zhu, F.; Jiang, C.; Liu, Q.; Cheng, Z.; Dai, G.; Wu, G.; Wang, L.; et al. Antibacterial activity and mechanism of silver nanoparticles against multidrug-resistant pseudomonas aeruginosa. Int. J. Nanomed. 2019, 14, 1469–1487. [Google Scholar] [CrossRef] [PubMed]
- Theophel, K.; Schacht, V.J.; Schluter, M.; Schnell, S.; Stingu, C.S.; Schaumann, R.; Bunge, M. The importance of growth kinetic analysis in determining bacterial susceptibility against antibiotics and silver nanoparticles. Front. Microbiol. 2014, 5, 544. [Google Scholar] [CrossRef] [PubMed]
- Kumar-Krishnan, S.; Prokhorov, E.; Hernández-Iturriaga, M.; Mota-Morales, J.D.; Vázquez-Lepe, M.; Kovalenko, Y.; Sanchez, I.C.; Luna-Bárcenas, G. Chitosan/silver nanocomposites: Synergistic antibacterial action of silver nanoparticles and silver ions. Eur. Polym. J. 2015, 67, 242–251. [Google Scholar] [CrossRef]
- Zienkiewicz-Strzałka, M.; Pasieczna-Patkowska, S.; Kozak, M.; Pikus, S. Silver nanoparticles incorporated onto ordered mesoporous silica from tollen’s reagent. Appl. Surf. Sci. 2013, 266, 337–343. [Google Scholar] [CrossRef]
- Langford, J.I.; Wilson, A.J.C. Scherrer after sixty years: A survey and some new results in the determination of crystallite size. J. Appl. Cryst. 1978, 11, 102–113. [Google Scholar] [CrossRef]
- Rabiej, M. A hybrid immune-evolutionary strategy algorithm for the analysis of the wide-angle X-ray diffraction curves of semicrystalline polymers. J. Appl. Cryst. 2014, 47, 1502–1511. [Google Scholar] [CrossRef]

| Sample | The Particle Size of Ag Nanoparticles from XRD Data L (Å) | Crystallinity (%) | Surface Area (SBET)1 (m2/g) | Pore Volume2 (cm3/g) | Pore Size Distribution3 (nm) | |||
|---|---|---|---|---|---|---|---|---|
| Diffraction Peaks (hkl) | ||||||||
| 111 | 002 | 022 | 311 | |||||
| Ag/CS/SiO2_007 | 266 | 161 | 195 | 197 | 46.9 | 8.5 | 0.018 | 2.8, 4.5, 7.8 |
| Ag/CS/SiO2_002 | 281 | 175 | 178 | 175 | 54.6 | 8.1 | 0.018 | 3.0, 4.6, 8.0 |
| Ag/CS/SBA-15 | 252 | 163 | 165 | 165 | 84.2 | 7.8 | 0.017 | 3.0, 4.6, 8.1 |
© 2019 by the authors. Licensee MDPI, Basel, Switzerland. This article is an open access article distributed under the terms and conditions of the Creative Commons Attribution (CC BY) license (http://creativecommons.org/licenses/by/4.0/).
Share and Cite
Zienkiewicz-Strzałka, M.; Deryło-Marczewska, A.; Skorik, Y.A.; Petrova, V.A.; Choma, A.; Komaniecka, I. Silver Nanoparticles on Chitosan/Silica Nanofibers: Characterization and Antibacterial Activity. Int. J. Mol. Sci. 2020, 21, 166. https://doi.org/10.3390/ijms21010166
Zienkiewicz-Strzałka M, Deryło-Marczewska A, Skorik YA, Petrova VA, Choma A, Komaniecka I. Silver Nanoparticles on Chitosan/Silica Nanofibers: Characterization and Antibacterial Activity. International Journal of Molecular Sciences. 2020; 21(1):166. https://doi.org/10.3390/ijms21010166
Chicago/Turabian StyleZienkiewicz-Strzałka, Małgorzata, Anna Deryło-Marczewska, Yury A. Skorik, Valentina A. Petrova, Adam Choma, and Iwona Komaniecka. 2020. "Silver Nanoparticles on Chitosan/Silica Nanofibers: Characterization and Antibacterial Activity" International Journal of Molecular Sciences 21, no. 1: 166. https://doi.org/10.3390/ijms21010166
APA StyleZienkiewicz-Strzałka, M., Deryło-Marczewska, A., Skorik, Y. A., Petrova, V. A., Choma, A., & Komaniecka, I. (2020). Silver Nanoparticles on Chitosan/Silica Nanofibers: Characterization and Antibacterial Activity. International Journal of Molecular Sciences, 21(1), 166. https://doi.org/10.3390/ijms21010166

